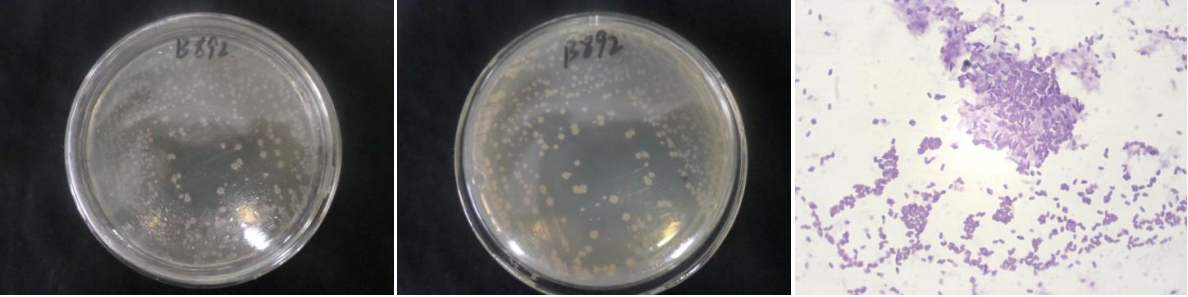

Loading...
| StrainNO | B892 |
| Classification | Paenibacillus |
| 16s rDNA sequence | GCTATACATGCAGTCGAGCGGGGTTGTGTAGAAGCTTGCTTCTAAACAACCTAGCGGCGGACGGGTGAGTAACACGTAGGCAACC TGCCCACAAGACAGGGATAACTACCGGAAACGGTAGCTAATACCCGATACATCCTTTTCCTGCATGGGAGAAGGAGGAAAGACGG AGCAATCTGTCACTTGTGGATGGGCCTGCGGCGCATTAGCTAGTTGGTGGGGTAAAGGCCTACCAAGGCGACGATGCGTAGCCGA CCTGAGAGGGTGATCGGCCACACTGGGACTGAGACACGGCCCAGACTCCTACGGGAGGCAGCAGTAGGGAATCTTCCGCAATGGG CGAAAGCCTGACGGAGCAACGCCGCGTGAGTGATGAAGGTTTTCGGATCGTAAAGCTCTGTTGCCAGGGAAGAACGTCTTGTAGA GTAACTGCTACAAGAGTGACGGTACCTGAGAAGAAAGCCCCGGCTAACTACGTGCCAGCAGCCGCGGTAATACGTAGGGGGCAAG CGTTGTCCGGAATTATTGGGCGTAAAGCGCGCGCAGGCGGCTCTTTAAGTCTGGTGTTTAATCCCGAGGCTCAACTTCGGGTCGC ACTGGAAACTGGGGAGCTTGAGTGCAGAAGAGGAGAGTGGAATTCCACGTGTAGCGGTGAAATGCGTAGAGATGTGGAGGAACAC CAGTGGCGAAGGCGACTCTCTGGGCTGTAACTGACGCTGAGGCGCGARAGCGTGGGGAGCAAACAGGATTAGATACCCTGGTAGT CCACGCCGTAAACGATGAATGCTAGGTGTTAGGGGTTTCGATACCCTTGGTGCCGAAGTTAACACATTAAGCATTCCGCCTGGGG AGTACGGTCGCAAGACTGAAACTCAAAGGAATTGACGGGGACCCGCACAAGCAGTGGAGTATGTGGTTTAATTCGAAGCAACGCG AAGAACCTTACCAGGTCTTGACATCCCTCTGACCGGTCTAGAGATAGACCTTTCCTTCGGGACAGAGGAGACAGGTGGTGCATGG TTGTCGTCAGCTCGTGTCGTGAGATGTTGGGTTAAGTCCCGCAACGAGCGCAACCCTTATGCTTAGTTGCCAGCAGGTCAAGCTG GGCACTCTAAGCAGACTGCCGGTGACAAACCGGAGGAAGGTGGGGATGACGTCAAATCATCATGCCCCTTATGACCTGGGCTACA CACGTACTACAATGGCCGGTACAACGGGAAGCGAAATCGCGAGGTGGAGCCAATCCTAGAAAAGCCGGTCTCAGTTCGGATTGTA GGCTGCAACTCGCCTACATGAAGTCGGAATTGCTAGTAATCGCGGATCAGCATGCCGCGGTGAATACGTTCCCGGGTCTTGTACA CACCGCCCGTCACACCACGAGAGTTTACAACACCCGAAGTCGGTGGGGTAACCCGCAAGGGAGCCAGCCGCCGAAGGTGGGGTAG ATGATTGGGGGAAGTCGTAACAATG |
| Strain Morphology Photos | |
| Morphological Description | Colony round;Lychee flesh white;edge serrated;Slightly convex on the edge;have concentric rings;multifold;slippy;sticky;Waxed;Rod;having spore;Mesophilic budding spore |